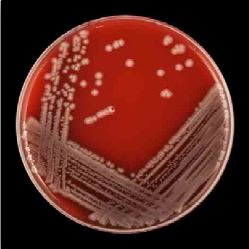
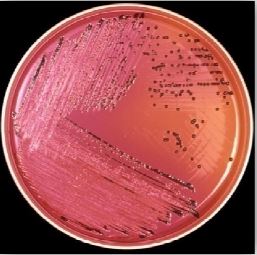
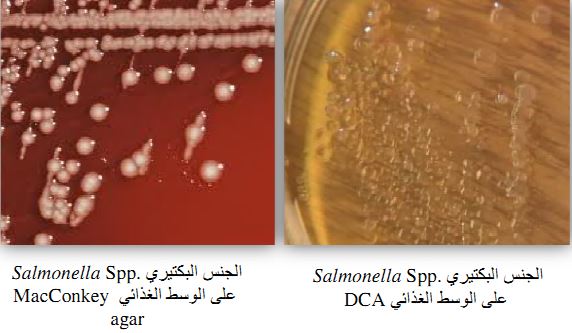
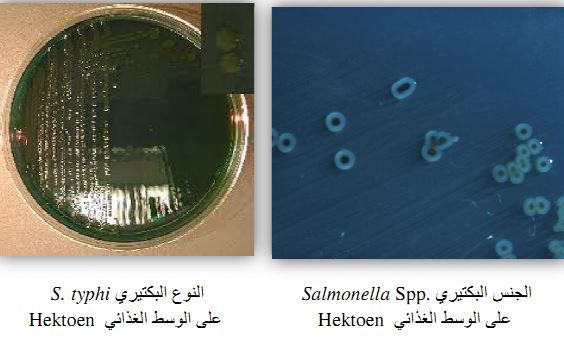
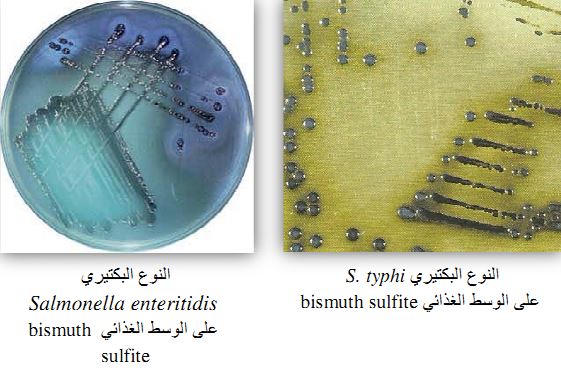
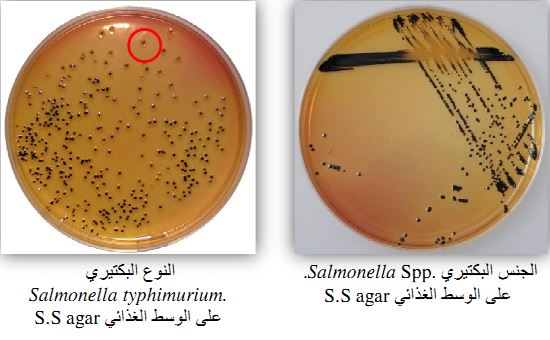

النبات

مواضيع عامة في علم النبات

الجذور - السيقان - الأوراق

النباتات الوعائية واللاوعائية

البذور (مغطاة البذور - عاريات البذور)

الطحالب

النباتات الطبية


الحيوان

مواضيع عامة في علم الحيوان

علم التشريح

التنوع الإحيائي

البايلوجيا الخلوية


الأحياء المجهرية

البكتيريا

الفطريات

الطفيليات

الفايروسات


علم الأمراض

الاورام

الامراض الوراثية

الامراض المناعية

الامراض المدارية

اضطرابات الدورة الدموية

مواضيع عامة في علم الامراض

الحشرات


التقانة الإحيائية

مواضيع عامة في التقانة الإحيائية


التقنية الحيوية المكروبية

التقنية الحيوية والميكروبات

الفعاليات الحيوية

وراثة الاحياء المجهرية

تصنيف الاحياء المجهرية

الاحياء المجهرية في الطبيعة

أيض الاجهاد

التقنية الحيوية والبيئة

التقنية الحيوية والطب

التقنية الحيوية والزراعة

التقنية الحيوية والصناعة

التقنية الحيوية والطاقة

البحار والطحالب الصغيرة

عزل البروتين

هندسة الجينات


التقنية الحياتية النانوية

مفاهيم التقنية الحيوية النانوية

التراكيب النانوية والمجاهر المستخدمة في رؤيتها

تصنيع وتخليق المواد النانوية

تطبيقات التقنية النانوية والحيوية النانوية

الرقائق والمتحسسات الحيوية

المصفوفات المجهرية وحاسوب الدنا

اللقاحات

البيئة والتلوث


علم الأجنة

اعضاء التكاثر وتشكل الاعراس

الاخصاب

التشطر

العصيبة وتشكل الجسيدات

تشكل اللواحق الجنينية

تكون المعيدة وظهور الطبقات الجنينية

مقدمة لعلم الاجنة


الأحياء الجزيئي

مواضيع عامة في الاحياء الجزيئي


علم وظائف الأعضاء


الغدد

مواضيع عامة في الغدد

الغدد الصم و هرموناتها

الجسم تحت السريري

الغدة النخامية

الغدة الكظرية

الغدة التناسلية

الغدة الدرقية والجار الدرقية

الغدة البنكرياسية

الغدة الصنوبرية

مواضيع عامة في علم وظائف الاعضاء

الخلية الحيوانية

الجهاز العصبي

أعضاء الحس

الجهاز العضلي

السوائل الجسمية

الجهاز الدوري والليمف

الجهاز التنفسي

الجهاز الهضمي

الجهاز البولي


المضادات الميكروبية

مواضيع عامة في المضادات الميكروبية

مضادات البكتيريا

مضادات الفطريات

مضادات الطفيليات

مضادات الفايروسات

علم الخلية

الوراثة

الأحياء العامة

المناعة

التحليلات المرضية

الكيمياء الحيوية

مواضيع متنوعة أخرى

الانزيمات
الجنس Salmonella Spp
المؤلف:
عبد الرزاق سليمان التومي ، محمد محمد الامام ، عبد الباسط رمضان
المصدر:
اساسيات التشخيص البكتريولوجي المعملي والسريري
الجزء والصفحة:
21-7-2016
9895
Salmonella Spp
هذا الجنس البكتيري عبارة عن خلايا عصوية الشكل سالبة لصبغة جرام وهو غير هوائي اختيارياً وغير مكون للأبواغ ويحتوي على العديد من الأسواط تساعده على الحركة ويتراوح طول الخلية ما بين 5-2 ميكرومتر وعرضها حوالي 1.5 – 0.8 ميكرومتر ويصنف هذا الجنس البيكتيري على أنه ممرض للإنسان والحيوان.

يعتمد تواجد هذا الجنس البكتيري في الطبيعة على وجود الحيوانات ومن أهم العوائل التي تساعد على تواجد هذا الجنس البكتيري الطيور الداجنة والفوز والماشية والقوارض والسلاحف والخنافس والقطط كما يمكن أن يستفيد من الإنسان كعائل carrier (وهم ما يعرفون بالأشخاص الحاملين للبكتيريا ) ويتم إحداث الإصابة عن طريق تناول الأطعمة الملوثة ببراز احد العوائل المصابة أو تناول لحوم الحيوانات المصابة حيث من الممكن أن يتلوث بهذا الجنس البكتيري أثناء عملية الذبح مع العلم بأن هذا الجنس البكتيري تم عزله من المياه الملوثة. ومن المعروف أن للجنس البكتيري Salmonella Spp. القدرة على النمو في درجات حرارة مختلفة (45-15 درجة مئوية) وفي معدلات مختلفة من الأس الهيدروجيني (8-4).
الامراضية :
هناك العديد من الإصابات التي يسببها الجنس البكتيري Salmonella Spp . منها داء الحمى المعوية enteric fever (التيفود والباراتيفود) يصاحبه تجرثم الدم bacteraemia ، هذه الإصابات يسببها النوع البكتيري S. typhi والنوع البكتيري S. paratyphi A, B, C وهي تتواجد في براز الشخص المريض والحامل للمرض carrier وتتم الإصابة من خلال تناول الأغنية الملوثة بما في ذلك المياه الملوثة أو من خلال تلوث الأيدي وينتقل النوع البكتيري S. typhi بصورة خاصة عبر المياه الملوثة (water – horne) اما النوع البكتيري S. paratyphi فهو غالباً ما يكون من مصدر غذائي (food - borne) . كما يمكن لهذا النوع البكتيري إحداث ما يسمى بالتهاب القولون المعوي enterocolitis وفي الغالب يسببها النوع البكتيري S. typhimurium والنوع البكتيري S. enteritidis وتحدث الاصابة بتناول الغذاء الملوث بهذا النوع البكتيري، وتعتبر الدواجن والبيض ومشتقات البيض من أهم الأغذية المسببة للمرض. من اهم الأعراض التي قد تظهر على المريض : الإسهال ، القيء ، الحمى والمغص وهذه الأعراض تظهر بعد 36-12 ساعة من تناول الغذاء الملوث. في الطور الحاد يمكن ملاحظة وجود المخاط mucus والدم في عينة البراز ويعتبر الأطفال والأشخاص كبار السن الذين يعانون من مشاكل صحية خاصة المصابين بالتهاب القولون التقرحي ulcerative colitis والأشخاص الذين يعانون من خلل في الجهاز المناعي أكثر عرضة للإصابة الخطيرة بهذا الجنس البكتيري. كما يمكن لهذا الجنس البكتيري إحداث التهاب الصفراوية gall bladder والتهاب العظام خاصة في الأطفال الذين يعانون من مرض الخلية المنجلية sickle cell disease ، وتجرثم الدم bacteraemia وكذلك تعفن الدم sepicaemia الذي غالباً ما يسببه النوع البكتيري S. typhimurium والنوع البكتيري S. enteritidis كما أن النوع البكتيري S. typhimurium يسبب التهاب السحايا في المواليد.


التشخيص المعملي :
لتشخيص حالات الحمى المعوية يتم تجميع عينات دم وبراز وكذلك عينة بول لإجراء المزرعة البكتيرية حيث من الممكن عزل هذا الجنس البكتيري في حوالي 90-75% من المرضى وذلك خلال العشرة أيام الأولى من حدوث الإصابة المرضية وفي حوالي 30% من المرضى خلال الإسبوع الثالث، في الإصابات المزمنة chronic salmonellosis قد تبين أنه يمكن عزل النوع البكتيري S. typhi من عينة نخاع العظم بسهولة أكثر من عينة الدم وخاصة إذا ما تناول المريض العلاج بالمضادات الحيوية. أما في عينة البراز فإنه يمكن
تحديد وجود هذا الجنس البكتيري بنسبة 50-40% خلال الاسبوع الثان من حدوث الإصابة وبنسبة تصل إلى حوالي 80% من المرضى خلال الإسبوع الثالث كما أن عينة البراز تفيد في عزل النوع البكتيري S. typhi في الأشخاص الحاملين للمرض carriers. اما في عينة البول فيمكن تحديد وجود هذا الجنس البكتيري في حوالي 25% من الحالات المرضية بعد الاسبوع الثاني من الاصابة خاصة الاشخاص المصابين بداء urinary schistosomiasis ، نظراً لأن هذا الجنس البكتيري لا يتواجد بصورة مستمرة في عينة البول لذلك لابد من تجميع عدة عينات للتمكن من عزله.
يتم استعمال وسط غذائي انتقائي لعزل هذا الجنس البكتيري من عينات البراز، قد يفصل استعمال حساء اغنائي انتقائي selective enrichment broth مثل الوسط الغذائي Rappaport Vassiliadis broth (عندما يعتقد أن المسبب ليس S. typhi) ولعزل النوع البكتيري S. typhi من عينة الدم يتم تلقيح العينة في وسط غذائي يتكون من 10% ox-gall في ماء مقطر (أضف 5 مل من الدم إلى 50 مل من الوسط الغذائي ox – bile) بعد ذلك يتم إعادة تنميتها على الوسط الغذائي Blood agar وحضانتها لمدة 24 ساعة. كما يمكن استعمال الوسط الغذائي Columbia agar – broth وهو وسط غذائي صلب وسائل معاً لعزل البكتيريا salmonellae والأجناس البكتيرية الأخرى التي يمكن أن تسبب تجرثم الدم bacteraemia بعد ذلك يتم إعادة تنميتها على الوسط الغذائي blood agar وحضانتها لمدة 24 ساعة.
ولعزل هذا الجنس البكتيري من عينات البيئة والأطعمة وعينات البراز يتم تحفيزه على النمو باستعمال أوساط غذائية انتقائية مغذية شائعة الاستعمال مثل Tetrathionate broth والوسط الغذائي Selenite F broth أو الوسط الغذائي Rappaport – Vassiliadis medium وبعد انتهاء عملية العزل المبدئي باستعمال الوسط الغذائي الانتقائي المغذي يتم تنمية المستعمرات التي يعتقد انها الجنس البكتيري Salmonella Spp في الوسط الغذائي Triple sugar iron agar أو Urea broth أو Lysine iron agar .
ــ الوسط الغذائي Blood agar : يستعمل كوسط ثان (subculture) وتظهر المستعمرات رمادية ــ بيضاء وبقطر 3-2 مم دون وجود إحلال لدم وبعض السلالات تكون لزجة القوام.
الجنس البكتيري Salmonella Spp على الوسط الغذائي Blood agar
ــ الوسط الغذائي XLD agar :
الجنس البكتيري Salmonella Sppعلى الوسط الغذائي XLD
تظهر مستعمرات البكتيريا Salmonellae المنتجة لكبريتيد الهيدروجين مستعمرات ذات لون وردي ــ أحمر وبقطر 5-3 مم مع وجود بقعة سوداء في المنتصف ، اما السلالات غير المنتجة لكبريتيد الهيدروجين مثل النوع البكتيري S. paratyphi A فهي تكون مستعمرات بكتيرية ذات لون وردي ــ أحمر وبقطر 5-3 مم مع عدم وجود بقعة سوداء في المنتصف تشبه إلى حد كبير شكل مستعمرات الجنس البكتيري Shigellae.
ــ الوسط الغذائي DCA agar والوسط الغذائي MacConkey agar :
السلالات البكتيرية غير المخمرة لسكر اللاكتوز يكون لونها باهت مع وجود بقعة سوداء في المنتصف مما يدل على إنتاج كبريتيد الهيدروجين.
ــ الوسط الغذائي Hektoen agar :
مستعمرات الجنس البكتيري Salmonella Spp تظهر بقعة سوداء في منتصف المستعمرة النامية والتي غالباً ما تكون شفافة اللون مما يدل على تكون كبريتيد الهيدروجين مع عدم القدرة على تخمير السكريات مع ملاحظة ان النوع البكتيري S.typhi ليس له القدرة على إنتاج كمية كبيرة من كبريتيد الهيدروجين.
ــ الوسط الغذائي bismuth sulfter agar : المستعمرات البكتيرية النامية قد يكونها لونها أسود أو أسود زيتوني مع إمكانية تكون غشاء أخضر لماع وهذا الوسط الغذائي يمكن نمو البكتيريا الموجبة لصبغة جرام وكذلك البكتيريا القولونية ، وهو يستعمل بصورة أخص لعزل النوع البكتيري S. typhi والأنواع البكتيرية الأخرى من النوع البكتيري Salmonella Spp من عينات الأغذية ومياه الصرف الصحي والعينات السريرية.
ــ الوسط الغذائي S.S agar : يعتبر وسطاً غذائياً انتقائياً ويستعمل لعزل الجنس البكتيري Salmonella Spp والجنس البكتيري Shigella Spp من عينات الاغذية والعينات السريرية ونظراً لإحتواء على أملاح الصفراوية bile salt فلا يمكن نمو البكتيريا الموجبة لصبغة جرام والبكتيريا القولونية والمستعمرات البكتيرية النامية يكون لونها شفاف أو عديمة اللون مع وجود بقعة سوداء في منتصف المستعمرات البكتيرية النامية أما النوع البكتيري S. typhimurium يكون لونها أصفر مع وجود البقعة السوداء في منتصف السمتعمرة البكتيرية النامية.
الاختبارات المعملية :
يتم استعمال الوسط الغذائي KIA (Kligler iron agar) كإختبار يساعد على تعريف هذا الجنس البكتيري وعزله حيث أن هذا الجنس البكتيري وسيعطي على النحو التالي:
ــ الجزء العلو من الإنبوبة Slope يكون أحمر ــ وردي (قلوي) ويكون لون قاع الانبوبة (butt) أصفر (حامضي) ، مما يدل على تخمر سكر الجلوكوز وعدم تخمر سكر اللاكتوز ، كما أن وجود تفرقعات في الوسط الغذائي الصلب يدل على انتاج الغاز من تخمر سكر الجلوكوز (النوع البكتيري S. typhi لا ينتج غاز) ، واللون الأسود المتكون يدل على تكون كبريتيد الهيدروجين H2S.
- اختبار الاندول وإنزيم اليورياز : سالب.
- اختبار الكشف على إنزيم Lysin decarboxylase (LDC) : موجب.
(النوع البكتيري S. paratyphi A سالب)
- اختبار سكر اللاكتوز : سالب.
- تكون الغاز من نخمر سكر الجلوكوز : النوع البكتيري S. typhi لا تنتج غاز.
- اختبار الكشف على السيترات citrate : النوع البكتيري S. typhi والنوع البكتيري S. paratyphi سالبة.
- اختبار B-galactosidase : سالبة.
يمكن تمييز النوع البكتيري S. typhi عن بقية الأنواع الأخرى من هذا الجنس البكتيري بأن تكون نتيجة اختبار الكشف عن السيترات سالبة، مع عدم تكون الغاز وتكون مقدار قليل من كبريتيد الهيدروجين ، وأي مستعمرة بكتيرية معزولة تعطي نتيجة موجبة لاختبارات الجنس البكتيري Salmonella Spp.
يتم تأكيد الاختبارات الكيموحيوية باستعمال الاختبارات المصلية polyvalent O group و polyvalent H group و Vi-antisera أو باستعمال التصنيف حسب نوع لاقمات الفيروسات phage – typing .

 الاكثر قراءة في البكتيريا
الاكثر قراءة في البكتيريا
 اخر الاخبار
اخر الاخبار
اخبار العتبة العباسية المقدسة

الآخبار الصحية















 قسم الشؤون الفكرية يصدر كتاباً يوثق تاريخ السدانة في العتبة العباسية المقدسة
قسم الشؤون الفكرية يصدر كتاباً يوثق تاريخ السدانة في العتبة العباسية المقدسة "المهمة".. إصدار قصصي يوثّق القصص الفائزة في مسابقة فتوى الدفاع المقدسة للقصة القصيرة
"المهمة".. إصدار قصصي يوثّق القصص الفائزة في مسابقة فتوى الدفاع المقدسة للقصة القصيرة (نوافذ).. إصدار أدبي يوثق القصص الفائزة في مسابقة الإمام العسكري (عليه السلام)
(نوافذ).. إصدار أدبي يوثق القصص الفائزة في مسابقة الإمام العسكري (عليه السلام)


















